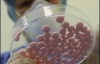
МОЗ складає "чорний" список ліків

Почався набір добровольців для участі у випробуваннях чоловічого контрацептиву, який вводитиметься ін"єкційний, повідомляє ВВС. Дослідження нового способу контрацепції ініційоване Усесвітньою організацією охорони здоров"я.
Суть нового способу контрацепції полягає в регулярному введенні двох гормонів: тестостерону і прогестерону. Ін"єкція цих препаратів буде робитись чоловікам що два місяця.
Тестостерон, впливаючи на клітини чоловічих статевих залоз за принципом негативного зворотнього зв"язку, викликає зниження вироблення сперматозоїдів. Прогестерон, який є жіночим гормоном, збільшує ефективність і тривалість дії тестостерона, а також дозволяє використовувати менші концентрації останнього для досягнення потрібного ефекту.
Після того, як концентрація сперматозоїдів в спермі знизиться до рівня, при якому зачаття неможливе, учасників дослідження попросять на рік відмовитися від інших способів контрацепції. На думку вчених, зміни в організмі чоловіків, викликані ін"єкціями гормонів, є тимчасовими.
Для участі в дослідженні, яке виконають співробітники 10 медичних центрів в Європі, Азії, Південній Америці і Австралії, відберуть близько 400 пар. При цьому вік учасника-чоловіка не повинен перевищувати 45, а жінки - 37 років. У Великобританії випробування нового контрацептиву проведуть співробітники Едінбурзького університету (Edinburgh University).

Коментарі